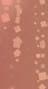

![]()




















































































By LANA EATHER
Want to help a wonderful organisation? Volunteering is a wonderful way to expand your skills and experience, increase your employability, and stay engaged with the community. It’s also a way for you to give back and help people who need a hand.
Vinnies urgently needs more volunteers in the Central West of NSW to help with retail and logistics operations. Vinnies relies on volunteers to fully operate the Orange Distribution Centre which sorts and transports donations to 15 Vinnies shops around the region. The distribution centre processed over nine tonnes of donated textiles each month producing 120 boxes of stock to be sent to local shops.
Vinnies throughout the region are desperate for volunteers to continue sorting items, assist customers, and help with day-to-day tasks. Those who give their time to volunteer with Vinnies are directly helping to raise vital funds and provide assistance to people who are experiencing homelessness, domestic and family violence, and poverty. Volunteers will meet like-minded people in a supportive team environment and make a difference for people in need while giving back to your local
community.
“We would be so grateful for anyone who can dedicate some time to helping with our retail operations in the Central West area,” says Retail Area Manager Danielle Curran. “Our volunteers are absolutely essential. They enable us to help people in need and make a bigger impact in our local community.”
Anyone who is interested in volunteering with Vinnies is encouraged to apply online or visit their local store to meet the team in person.
In the past financial year, approximately 5750 retail and logistics volunteers helped Vinnies to sell over 3.4 million items of pre-loved clothing and goods around the state. “Vinnies volunteers share our vision of a more just and compassionate society,” says Ms. Curran. “They may have busy lives, but sparing just a few hours during the week, or a day on the weekend, can make a huge difference.”
In the past year, St Vincent de Paul Society NSW assisted over 8000 individuals in the Central West region and distributed over $1m in financial and material assistance to residents in need. Of the people reaching out, 84 per cent needed food assistance and 35 per cent were experiencing housing stress.







THREE

Do you have a nickname? Nick. Where did you grow up? Dubbo.
What do you like to do in your spare time? Spend my pay cheque.
Do you have any hidden talents or special skill? Not that I know of!
If you could only eat one meal for the rest of your life, what would it be? Steak.
What are you watching at the moment? Severance.
What would you be lost without? My phone. What music do you like to listen to? Good tunes.
Favourite song of all time? Glimmer by Mako Road.
What is your all-time favourite movie? Casino Royale.
If there was a movie all about you, who would play you? Idris Elba.
If you could go back in time, what year would you travel to and why? AD79, Pompeii.
What do the next five years look like for you? Studying in Sydney.
















By LANA EATHER
MACQUARIE Anglican Grammar School
Year 10 student Caison Duncan has been selected for the Pacific Nomads Rugby ream. Caison earned his spot based on his impressive performances in the Crescent Head and Tuggerah Ella 7s tournaments.

















In early November, Caison will travel to the Cook Islands to compete in the prestigious Raro 7s competition. Caison enthusiastically adds: “This tour offers an incredible experience on and off the field, with team bonding and cultural immersion. I am very honoured, and I am willing to represent my family and culture in this event, with hopes to educate others about my people as well. This tournament presents an open learning experience for both the game of Rugby 7s, as well as the opportunity to learn about the Cook Islands’ culture.”
Purrfect time to get a kitten or puppy at adopt-a-pet days



Now’s the purrrfect time to get yourself a new furry friend, with Dubbo Animal Welfare League’s March Madness promotion on for the rest of the month.
This means that locals can adopt a desexed, vaccinated, micro-chipped and lifetime-registered cat or kitten for the basement-low price of just $100.
If you’re more of a canine kind of carer, you can also pick up a puppy or pooch at their
three upcoming Adoption Days being held at local pet supply retailers.
Dogs and cats, puppies and kittens, are all available to go to a new home from Petbarn, Dubbo (Unit A, Mitchell Highway and Sheraton Road) on Saturday, March 22, and from Pet- stock (54 Bourke Street) on Sunday, March 23, and on Saturday, April 5, all from 10am–2pm.
For more information, contact AWL Dubbo on 0400 851 781.









































































































































































































































By

IT’S been a four-year saga that finally has clarity: Brisbane will get a new stadium when it hosts the 2032 Summer Olympic and Paralympic Games.
This is a tale of broken promises, constantly-changing plans, and – in the interests of balance – a pragmatic decision to build a new 63,000-seat stadium at Victoria Park in Brisbane’s inner-north, within 5km of the city CBD.
Queensland Premier David Crisafulli broke a promise he made to the state, before the 2024 election, not to build a new stadium. .
However, as ABC reported, Mr Crisafulli believed a new stadium at Victoria Park was a “clear” choice.
And Mr Crisafulli felt he broke his pre-election pledge for the right reasons: “The games must be held at a new stadium at Victoria Park,” Mr Crisafulli told the ABC. “Any other choice would have meant placing the government’s interests ahead of the interests of Queensland. We’ve had enough of that in the last few years and I wasn’t prepared to do that.”
The International Olympic Committee (IOC) could not have forecast how critical it was to officially announce Brisbane as the host city way back in July, 2021, 11 years before the games.
If the IOC had waited until now to announce Brisbane as the host, it’s doubtful the games would have been ready in time after the first four years of lead-up time have been wasted.
A venue that wasn’t going to be ready by 2032 due to that four-year



delay, according to Mr Crisafulli, was The Gabba, an iconic ground of Australian sport that has hosted the 2020 AFL grand final and first hosted Test cricket back in 1931.
The Gabba was originally mooted to be the major host venue of the 2032 Olympics with a refurbishment planned.
However, plans got delayed and Mr Crisafulli said there was “no longer time” to upgrade the Gabba, adding the new Victoria Park plan would deliver “for 2032 and beyond”.
Now it is set to host cricket, if that sport proceeds at the Brisbane Olympics, and be knocked down after the games.
“It became a choice between spending billions on temporary facilities and temporary stands that delivered no legacy (and did not) secure the future of AFL and cricket at a new home,” Mr Crisafulli told Fox Sports.
“It became a choice between delivering a games with an eye to the future or rewinding the clock for decades. In the end, the choice was clear. The games must be held at a new stadium at Victoria Park.”
After the 2032 Olympics and Paralympics, Victoria Park is set to be new home of the Brisbane Lions (AFL), Brisbane Heat (Big Bash League cricket), and Test cricket.
A legacy is planned for after the games, much like the Sydney 2000 Olympics which benefit-
ted from Stadium Australia (now Accor Stadium) being reconverted into an 82,000 seat facility for multiple sports, Qudos Bank Arena (capacity 18,000 for basketball and 21,000 for concerts) is now a premium basketball and entertainment venue, and the Sydney Showground’s Engie Stadium (capacity 23,500) the home of Big Bash League cricket’s Sydney Thunder and the Greater Western Sydney Giants in the AFL.
Brisbane city will also benefit from a new national aquatic centre at Spring Hill with a capacity of 25,000 people that will become the home of Australian water sports, while the RNA Showgrounds will host the athletes village and an upgraded 20,000-seat arena will host key events and a new 3000seat show court area and 12 match courts will be built at the Queensland Tennis Centre.
Regionally, Rockhampton (rowing), Townsville (football and sailing), the Whitsundays (sailing), Gold Coast (hockey, triathlon, basketball), Maryborough (archery), Toowoomba (equestrian), Cairns (football and basketball), Mackay (cricket if included in games), and the Sunshine Coast (mountain biking and possibly football), are all set to be part of the games.
The only loser of this drawn-out saga seems to be The Gabba.
After the 2032 Olympics and Paralympics, it is set to be demol-
ished and redeveloped into an entertainment and housing hub.
This will put an end to 137 years of being an iconic sports facility in Brisbane.
Australia’s national Test cricket side has played 67 Tests at The Gabba, winning 42, drawing 14, and losing 10, according to ESPN Cricinfo.
Famously dubbed the “Gabbattoir”, until recent seasons it traditionally it held the first test of any international test cricket series. Visiting sides often lost that crucial first clash on a wicket that often had plenty of grass and offered batters and bowlers equal opportunity.
The Gabba was also the venue of one of only two tied Tests ever in international cricket: when the Australia played the West Indies from December 9-14, 1960.
West Indies scored 453 before the Australian team amassed 505 for a 52-run lead on the first innings. The West Indies then posted 282, leaving Australia 233 in 69 overs for victory.
Australia was in all sorts of trouble at 6-92, before a 134-run partnership between all-rounder Alan Davidson (80) and captain Richie Benaud (52) bought the host back into the contest.
However, chasing victory, they lost their last four wickets for six runs, with Ian Meckiff run out chasing the solitary run that would have sealed victory.
The Gabba is a shortened term, with the ground’s name based on the suburb name it is located in, Wolloongabba.
The land on which the ground sits was first set aside for use as a cricket ground in 1895, and then shared first-class matches with the Brisbane Exhibition Ground, before hosting its first Test match in 1931 and becoming the preferred venue of Queensland and Australian cricket.
While The Gabba has been branded as “not fit-for-purpose” in recent times, with the key issue being the inability of an ambulance vehicle to access the playing surface if required, it is important to note from an historical context that the recent developments between 1993 and 2005 made The Gabba an all-seat stadium and far better venue than it previously was.
As recently as 1993, the ground only had a capacity of around 20,000 people (including hills) and – between 1972 and 1993 – had a dog track around it as well.
The rise of Australian Rules football in Queensland prompted to government to increase the playing surface size to host the Brisbane Bears (now Brisbane Lions), meaning the end of greyhound racing.
Almost 40 years after that 1993 call to end the dogs, The Gabba will sadly end its time as a major sports venue in 2032.























































































































SUNDAY 4 MAY 2025 9:30AM - 3:30PM


Contributed to Dubbo Photo News by THE INNER WHEEL CLUB OF DUBBO
MEMBERS of the Inner Wheel Club of Dubbo were joined by members of Dubbo West and Macquarie Rotary Clubs, friends, and even two dogs at Jubilee Oval to ‘Walk Two For Ten’ on Sunday, March 16.
The aim being to walk two kilometres and donate ten dollars to Cord Blood Research, the national project of Inner Wheel Australia. Sponsors also donated generously to the walk.
Cord blood research is based on the stem cells from cord blood collected at birth.
These stem cells are similar to those found in bone marrow and are used to treat a range of blood disorders and immune system conditions such as leukaemia, anaemia, and autoimmune diseases. Stem cells are largely used in the treatment of children.
Latest studies include mapping the immune deficit in Type 1 diabetes, brain injuries in preterm babies, and cerebral palsy. They are also used in adults following chemotherapy, stroke, heart disease and diabetes.
Each year grants for medical research are awarded from money raised by members of Inner Wheel Clubs throughout Australia. Nearly $4 million has been raised, and 64 grants awarded.
Following the walk, the fun continued at Devil’s Hollow Brewery with friendship and coffee.
If you would also like to donate to this worthy cause, or find out more contact the Inner Wheel Club of Dubbo, contact iiw.au.dubbo@gmail.com















By DAVID DIXON
IT’S great when you see a good deed receiving the recognition it deserves.
A recent ‘Thumbs Up’ by a reader acknowledging a local firm – Fargo’s Auto Service and Wash whose staffers, Jason and Nathan, had changed the flat tyre for an 86-yearold lady attending a medical appointment – has had a heart-warming sequel.
Following the incident, Fargo’s owner was later contacted by the lady in question with a “thank you” letter, and reviving an old Australian tradition.
“She also dropped a lovely card in, with a nice note, and cash to buy a beer each!” the owner explained, after he contacted Dubbo Photo News
“I want her to know we saw the ‘Thumbs Up’, we got the cash for a beer, and we would do it all again for NOTHING; what goes around comes around,” the owner said.
“The lady wrote: ‘Thank you, thank you, thank you both for your kindness and compassion, the world will still be a great place to live in with young men like you’. Well, the same goes for YOU, you have helped shape the world we live in! A simple thank you, but to know there are still people who appreciate the little things, it’s amazing, ” Fargo’s owner said.
ABOVE: The thank you letter to Jason and Nathan from Fargo’s Auto Service and Wash, for a good deed for a local lady, accompanied by money for a beer each.


Apr 3: Jane Goodall, British primatologist, 91. Alec Baldwin, US actor, 67. Shane Connor, Aussie actor, 66. Eddie Murphy, US actor, 64. Mark Skaife, race car driver, 58. Ben Mendelsohn, actor, 56. Jennie Garth, US actress, 53. Israel Folau, rugby union player, 36. Josh Hall, footy player, 35. Sophie Delezio, inspirational survivor, 24.
Apr 4: Craig T Nelson, US actor, 81. Kerry Chikarovski, former politician, 69. Hugo Weaving , actor, 65. Graham Norton, Irish talk show host, 62. Robert Downey Jnr, US actor, 60. Jason Stoltenberg , tennis player, 55. Nathan Blacklock , played league and union, 49. Sam Moran, former Wiggle, 47. Sam Frost, TV personality, 36. Justin O’Neill , footy player, 34.





Apr 5: Agnetha Faltskog , of pop group ABBA, 75. Ian Macfarlane, former politician, 70. Peter Overton, newsreader, 59. Pharrell Williams, US rapper/producer, 52. Quade Cooper, rugby union player, 37. Apr 6: Billy Dee Williams, US actor, 88. Graeme Base author/illustrator, 67. Paul Rudd, US actor, 56. Zach Braff, US actor, 50. Candace Cameron-Bure, US actress, 49. Oscar Piastri, Formula One racing driver, 24. Apr 7: Francis Ford Coppola , US film director, 86. Janis Ian, US singer, 74. Jackie Chan, movie star, 71. Russell Crowe, actor, 61. Duncan Armstrong , swimmer, 57. Mitchell Pearce, footy player, 36. Apr 8: Julian Lennon, English pop singer and son of John, 62. Robin Wright Penn US actress, 59. Patricia Arquette, US actress, 57. Sami Lukis, TV presenter, 55. Toutai Kefu rugby union player, 51. Grace Sewell aka Saygrace, singer, 28. Apr 9: Dennis Quaid, US actor, 71. Jamie Redfern, former Young Talent Time member, 68. Marc Jacobs, US fashion designer, 62. Cynthia Nixon, US actress, 59. Jacques Villeneuve, Canadian race car driver, 54. Jarrod Mullen, footy player, 38. Kristen Stewart, US actress, 35. Elle Fanning , US actress, 27.
These are the items that can be disposed of in your FOGO green-lid bin:
•Fruit and vegetables
•Meat, fish and eggs
•Dairy
•Tea leaves and coffee grounds
•Bread, rice and pasta
•Left-overs, expired foods and bones
•Grass clippings, flowers, weeds, prunings and branches up to 15cm diameter
•Council provided caddy liners
Cardboard, newspaper, paper towel, compostable packaging and tea bags are no longer to be placed in your FOGO green-lid bin due to regulation changes in 2022.
Scan the QR code to find out more about your domestic waste services.


By DALLAS REEVES
IMAGINE being able to have a blood test while picking up your medication and then find out the results within 15 minutes without initially having to see a Doctor then have pathology.
That could be the new normal in Australia with a pilot program currently underway at Orana Mall Pharmacy (OMP).
OMP managing partner Lisa Gibson has just returned from the annual Australian Pharmacy Professional Conference and Trade Exhibition (APP) on the Gold Coast from March 20-22.
APP brings together up to 7,000 professionals from across the pharmacy industry for networking, upskilling and professional development each year.
Lisa spoke on the panel on the opening day to discuss the role of pharmacists in primary care, particularly in rural and remote areas.
The panel focused on ‘How Community Pharmacy Can Strengthen Their Primary Care Role Through Precision Health’.
Lisa was joined on the panel by Jeff Harrell (national president, national community pharmacists association, USA), Dennis Bastas – executive chairman and group CEO, DBG Health; Professor Trent Twomey (national president, The Pharmacy Guild of Australia) and fellow regional pharmacist Karen Carter (owner, Carter’s Pharmacy Gunnedah and Narrabri Pharmacy).
Australia’s prime minister Anthony Albanese also took to the stage on the opening day of the conference to announce the prescription co-payment reduction, alongside Federal Minister for Health and Aged Care, Mark Butler.
When Lisa spoke to the audience, she was able to inform them about the pilot program that Orana Mall Pharmacy is part of where people can have their cholesterol and HbA1c tested.
The HbA1c test is a blood test that can be used to help screen for and diagnose diabetes and elevated blood glucose levels in patients. The testing was used to screen for patients with high cholesterol, diabetes, pre-diabetes or if they already have diabetes, how well it

is being controlled.
Orana Mall Pharmacy would “opportunistically screen patients” as they came in.
Some patients also heard they could have the testing for free and came in to be tested.
Of the 111 tests already conducted, 90 people were referred onto a doctor for further review including interventions for high cholesterol, high blood pressure, diabetes or pre-diabetes.
The pilot program started late last year and is continuing for another three months. It only takes around 15 minutes for the testing and results.
It is all about pharmacists being able to expand their scope of practice and safely follow protocols for referral when necessary.
In this way pharmacists aim to take pressure off our already congested doctors and primary health services.
“Rather than going to your GP, getting a referral for pathology, having the blood test, and then
waiting a few days, then going back to the GP, this is point of care testing,” Lisa explained.
“In the pharmacy, you can have the testing and get your results all then and there.”
Pharmacists have been increasing their “scope of practice” in recent years and hope they can implement a program beyond simply screening.
The other machine Orana Mall Pharmacy has as part of the pilot tests for COVID-19, Influenza A, Influenza B and strep throat.
Pre COVID-19, all pharmacists were generally allowed to do was flu vaccines.
Now can they vaccinate for COVID-19 and most vaccinations for overseas travel without the need for a prescription and seeing a Doctor.
“We’re hoping for something like this, we could potentially have screening and then be trained to provide treatment,” Lisa said.
“We are hoping that in the future we can support other primary

care health workers (general practitioners, nurse practitioners)... take the burden off them and allow them to work to the top of their scope and manage more chronic and complex cases.
“We could do potentially provide treatment because they have tested positive for COVID-19 or Influenza or they need treatment for strep throat.
“Rather than just screen and refer, we are hoping one day we can screen and treat.”
This is an area Lisa has always been passionate about.
Lisa said her overseas colleagues in America and Canada can already do this.
“The point of care testing is an opportunity to bridge that gap and reduce rural disadvantage that our parents can sometimes face in comparison to our metro counterparts,” she said.
“It’s about making modern technology and practices accessible for people in rural areas.”
Automation, including robotic
packing and dispensing, was another topic covered at the APP.
“Anything that is new and great in pharmacy features at the conference” Lisa explained.
“It’s a good opportunity to see what ways we can make community pharmacy better, in particular in rural and regional Australia”
Born and raised in Dubbo, Lisa did not know what she wanted to do when she finished school.
Her mother, Mariette, suggested pharmacy and Lisa decided to study pharmacy at The University of Sydney.
The former St John’s Primary School and St John’s College student came back to Dubbo from Sydney after university to complete her pharmacy internship. Lisa has worked at Orana Mall Pharmacy since 2004.
She rose up the ranks fast, beginning as a pharmacy student, then intern, then a registered pharmacist before becoming managing partner, a role she has been in for 18 years.

I NFLUENZA, or the flu, is a highly contagious viral infection caused by the influenza virus. Unlike the common cold, influenza can be serious for some people and lead to complications such as pneumonia or other breathing difficulties.
The best way to protect yourself and those around you is by getting the influenza vaccine. Vaccination reduces the severity of illness, lowers your risk of hospitalisation, and helps prevent influenza-related complications. With influenza season peaking during winter, autumn is the perfect time to arrange your vaccination.
Influenza often spreads through droplets from coughing or sneezing, and can also be transmitted by touching contaminated surfaces. People with the flu can also spread the virus for a couple of days before showing symptoms. Adults remain

infectious for about 3–5 days, while children can spread the virus for up to 10 days. Those with weakened immune systems may be contagious for even longer.
By STAFF REPORTERS
In the year 1900, newspapers were the main form of public communication, did you know?
Henry Lawson and Banjo Paterson were also making their names as famous bush authors, and Australia’s first print media organisation was founded in 1900.
For 125 years, the member newspapers of Country Press NSW Inc have told the stories of the people of regional NSW.
Now it is your chance to be a modern-day Lawson or Paterson by entering Country Press NSW’s state-wide commemorative challenge for creative writing… and maybe even see your story published in the pages of your local newspaper!
The competition has categories for primary school, second- ary school, and open age (for adults).
Entries close in early July and will be judged by the Fellowship
of Australian Writers NSW, with results announced in Term 4 this year.
Unlike many other writing competitions which have entry fees attached, Country Press NSW’s writing competition is FREE to enter. There will be a range of prizes provided.
We hope you will spread the word about the competition in your community – especially to those people you know who love to write or might like to pick up a pen.
The entry form for the competition available online, or drop into the of fice of any masthead that is part of the Country Press NSW network, and pick up a copy. Country Press NSW affiliated mastheads in central west NSW include those in our newspaper group: Nyngan Weekly, Narromine Star, Gilgandra Weekly, Warren Star, Dubbo Photo News , and Orange City Life.

If you experience fever, chills, cough, sore throat, muscle aches, headaches, tiredness, or nausea, you may have the flu. Children may also experience tummy pain, vomiting or diarrhoea. If you are unwell, it’s important to stay home and avoid contact with others to prevent further spread.
Some people hesitate to get the flu shot due to common misconceptions. One myth is that the vaccine can give you the flu – this is not true. The vaccine contains inactivated virus and other components that help your immune system recognise and fight the flu without causing illness.
Another myth is that only the elderly or those with health conditions need the vaccine. In reality, anyone can catch and spread the flu, and even healthy individuals can experience severe complications. By getting vaccinated, you can reduce your risk of severe illness and help protect those around you, especially vulnerable groups such as young children, pregnant women, and people with chronic conditions.
Influenza viruses change frequently, and multiple strains often circulate in the community. That’s why a flu vaccine is updated every year to offer the best protection. Influenza vaccination is free for many of those at-risk of more serious infection under the National Immunisation Program (NIP), and is expected to be available from April 2025 - ask your GP or pharmacist for more information.

AUTHOR BIO
Dr Paul Roth is a local GP and Senior Lecturer at the University of Sydney School of Rural Health






















































































OnSaturday, March 29, the first inaugural Tradies Ball was held at Dubbo RSL Club to raise money and awareness for men’s mental health charity; ‘Tradies in Sight’.

The Ball was an initiative by DubboPhotoNewsand those in attendance were treated to a delicious buffet-style meal and an amazing dessert by the catering team at the RSL.
The highlight of the night was a Q+A session with Paul Hausia from B2B Abilities, founder of Tradies in Sight, Bruno Efoti and DubboPhoto Newsgeneral manager, Lucie Peart about the importance of speaking about mental health and the unique challenges that men face when trying to reach out for help.

Bruno spoke about the need for increased funding or donations to the charity as more and more people are reaching out to the community-based organisation for help.
The night was topped off with an amazing performance by renowned rock band, ‘Ballz n All’ with Ball attendees taking to the dance floor to dance the night away.
The event raised over $5000 on the night through raffle ticket sales for Tradies n Sight with Bruno thanking sponsors and attendees for believing in the charity’s mission and message.
















































By DALLAS REEVES
A PASSION for helping and healing others has led Kacie Chater to open a pair of unique wellness businesses in Dubbo.
Kacie operates Kacie Chater Coaching, and Glow Inside & Out Colonics, from her Asset Way headquarters.
Glow Inside & Out Colonics is your holistic destination for professional, informative, and safe, colonic irrigation treatment.
The business offers colon cleansing (colonic irrigation) services to help individuals maintain overall health, as well as colon hydrotherapy, gut health supplements, therapeutic implant, and enemas.
Regular colonic irrigation can help people remove toxins, improve nutrient absorption, and reduce stress levels.
At her second business Kacie Chater Coaching, Kacie works on ensuring clients can heal core wounds, and break free from past trauma using scientific techniques and processes to im-
prove confidence and help people be in control of their emotions.
She uses the innovative release, heal, and glow method to go beyond merely addressing symptoms, focusing on uncovering and addressing root causes of personal issues to enable healing at a core level.
“I love helping people heal from a holistic point of view,” she said.
“I look at their mind and body as one. It is important to find out what’s going on at a deeper level to allow people to heal. I love allowing people to feel their best and thrive.”
Within colonics, Kacie can help clients with finding solutions for digestive issues, bloating, gas, feeling sluggish or fatigued, having brain-fog, or those who simply want to detox.
Kacie added looking after your bowel health is very important: Bowel cancer has increased 40 per cent, statistics state.
“I feel there isn’t enough education around the importance of bowel and gut
health and the follow-on effect it has on both physical, mental, and emotional well-being,” she said.
One to three bowel movements a day is considered healthy and normal. Anything less is a sign of constipation. At any point people have between two and seven kilograms of old waste sitting inside of their colon/ large intestine.
“Healing starts from the inside out, not just addressing the symptoms,” Kacie says. “Colonics are a fantastic way to help them achieve their goals. They can really focus on eliminating toxins, inflammation, and bad bacteria out of the body. That allows them to start to heal their gut and get their gut microbiome back into balance.
“That has a ripple effect on how they feel, their motivation and can improve their quality of life.”
Her coaching business is also experiencing growth as people learn how to improve their mental health.
“Business has been amazing,” Kacie said. “Dubbo
has welcomed the businesses with open arms. People are very open-minded to this approach to health and wellness. People are seeing amazing results.”
She is a master certified coach and master certified practitioner of Neuro Transformation Therapy, and a master certified practitioner of Timeline Transformation Therapy.
She helps clients with their sub-conscious mind and nervous system to release and heal trauma, depression, and anxiety.
Within colonics, she is a certified colon hydrotherapist and completed further training at a Brisbane clinic.
A former jockey for 14 years, Kacie started working in the racing industry when he was 16 and had her first race ride when she was 18. She did most of her racing around the Central West, eventually deciding to leave the sport in February, 2020, to pursue her passion to help others.


To get in touch with either business, go to: www.kaciechater.com
Kacie Chater
Where do you work?
Business owner of Glow Inside & Out Colonics and Kacie Chater Coaching. What’s your job? Master neuro transformation practitioner and timeline practitioner and colon hydrotherapist. Why do you Love Your Work? Because I help people heal from the root cause and not just address the symptoms. I allow people to feel good from the inside out. If you could work anywhere in the world, where would it be, and why? I love my job and what I am doing at the
What was your first paying job? Working as a stable hand in the horse racing industry. What three words would your friends use to describe you? Passionate, caring and a little pocket rocket. How would you spend a win of a
I would invest half of it, pay my house off, take myself and my partner on a holiday to Canada and Alaska, and also give my loved ones some money. Which actor would you have play you in the movie about your life? Julia Roberts.
to the situation.
Ability to work 12hr shifts on a 24hr r otating roster. (4 days on, 5 days off ).
If you’re interested, please apply via seek.com.au/NSW-Ambulance-jobs Visit NSW Ambulance Careers page on ambulance.nsw.gov.au/careers

If you have a unique or interesting job, a career opportunity or a fascinating learning option you’d like to share, get in touch with Dubbo Photo News now. To contribute ideas, email dubboworks@dubbophotonews.com.au


THE Central West Riders Social Motorbike Club (CWRSMC) have a new ride and a new community fund-raising venture coming up as they aim to continue to help those in need.
Based in Dubbo, the CWRSMC has been in operation since 2018 and one of the motorcycle club’s primary aims is to fundraise for the benefit of others, co-founder Darrel Harvey said.
Always looking to assist, this ride will support Country Hope, a charity supporting families who have a child with cancer or another life-threatening illness.
CWRSMC’s April ride will start at Devil’s Hollow Brewery. The group will then ride on to Dunedoo, then Mendooran (stopping for morning tea), before travelling back to Dubbo.
After the ride is completed, the group
will return for a family fun afternoon at the Amaroo Hotel.
The event will feature a raffle and auction to raise funds for Country Hope. It costs $20 for riders and $10 for pillions (passengers) to ride. Central West Riders SMC merchandise will also be for sale.
For the kids, there will be free activities including face-painting, a jumping castle, and the chance to meet-and-greet with characters like Elsa, Spiderman, and Kung Fu Panda. Mr Harvey confirmed his organisation has around 90 financial members, but around 800 people on its public group via social media.
The group does not care if people attend one ride or volunteer a ton of time to their group, they just enjoy connecting community and helping people.
Mr Harvey confirmed the group is appreciative of Robertson’s Motorcycles


and Fully Promoted Dubbo for their support with prizes.
Mr Harvey confirmed that all profits that CWRSMC makes from any event goes straight to the listed charity they are fund-raising for. “As a group we are able to conduct rides in a charity’s name, and events where we raise money to fund these charity rides; this way, every cent raised is given to the charity. To be able to hand a charity a large amount of money is an awesome experience.”
CWRSMC have raised money for organisations like Capes 4 Kids Australia Inc, Orana Support Service, and the Australian Skin Cancer Foundation previously among others.
The latest ride is on Saturday, April 5. The ride begins at 9.30am, with the fundraiser at 12.30pm.

By LANA EATHER
With the Easter Bunny soon to arrive on our doorsteps, local mother Jodie Wright is keen to give him a helping hand by organising the second year of the Dubbo Easter Egg Hunt. After moving to Dubbo and having two young children Jodie saw an opening for this fun annual event to bring together children, their families, and carers.
With a successful event in 2024, Jodie has visions of expansion with the Easter Egg Hunt now being held in Dubbo’s Victoria Park. This year’s hunt on Sunday, April 13, at 11am will see all the favourites return, with ice cream, colouring, face painting, coloured hair and hair glitter. What more could we want? That’s right… EASTER EGGS!!!
Event organiser Jodie is excited: “This year we are planning separate areas for all the different age ranges with a zone for the young crawling children, another for 1-5-year-olds and 5-10-year-olds. We also planning a gluten-free dairy free section as well. We really just want to give families a chance to come along, socialise, and have a great morning out.”
Donations of Easter goodies are appreciated, with sponsors and volunteers welcome to reach out to Jodie on 0448925151 for more details.
Transport for NSW, in partnership with Dubbo Regional Council and the Dubbo community, is progressing plans to name the New Dubbo Bridge.
You are invited to provide feedback on the Wiradjuri names shortlisted by the local First Nations community and/or Sunday 4 May 2025
Find out more www.haveyoursay.nsw.gov.au/ new-dubbo-bridge dubboprojects@transport.nsw.gov.au
1800 803 818
HAVE YOUR SAY



Keiran and Hannah’s chose Harry’s For Menswear to dress the bridal party. Every detail was thoughtfully chosen to create a breathtaking celebration.Keiran looked impeccable in a white Gibson tuxedo, complementing his radiant bride. His patent leather shoes added a sleek touch. His groomsmen contrasted sharply in classic black tuxedos, perfectly matching the bridesmaids’ elegant black gowns.The bridal party’s seamless coordination added timeless charm, ensuring the couple was surrounded by a picture-perfect group of loved ones. Their stylish, refined look set the stage for an unforgettable celebration.

Ange and Conner McDonald brought timeless style to their big day, with Conner looking effortlessly sharp in a classic black Cambridge suit. The sleek, tailored look wasn’t just for him—his groomsmen followed suit (literally), creating a dashing lineup of well-dressed gentlemen. Their crisp black ensembles perfectly complemented Ange’s breathtaking gown, making for a stunning contrast that highlighted just how radiant the bride was. With love in the air and style on point, the McDonalds’ wedding was as picture-perfect!


































By DALLAS REEVES
A SUCCESSFUL first instalment of the Castlereagh Maiden Merino Ewe competition held in March means the event will be split into east and west sections.
Brad Wilson, a stud stock sheep specialist for NSW with Nutrien Ag, based in Dubbo, was one of the co-ordinators of the inaugural competition.
This competition covered an area from Eumungerie and Kickabil all the way through to Collie and Gulargambone and then back to Mendooran and Merrygoen.
Eight competitors each entered their maiden Merino ewes for the event held on Tuesday, March 4. Peter, Ann and Doug Freeth –trading as Glenburn Holdings, Collie – were the winners.

The Bennetts family from Merrygoen, east of Mendooran, placed second.
Third place was Reg and Robyn Sweeney and Angus and Rowena Munro – trading as Pinehurst Pastoral – also at Merrygoen.
The encouragement award went to the Bonnington family – trading as John Bonnington and Co –from Curban.
Competition winners, the Freeth family, have the opportunity to represent the Castlereagh competition at the state final held in conjunction with the Merino National show at Dubbo in August this year.
Mr Wilson said next year the Castlereagh Merino Ewe competition will be held east of the Newell Highway from Merrygoen to Tooraweenah and places in
between.
IN 2027 it will be held west of the Newell Highway and include centres like Collie, Curban, and Kickabil.
“We will split it up east and west of the Newell (Highway) and do it as a biannual event,” he said.
Mr Wilson said industry knowledge meant he knew the Castlereagh area had a lot of good wool and sheep producers, so beginning a competition to recognise Merino producers in the area had been a thought for a little while.
“We’d been thinking about it for a few years,” Mr Wilson said.
“There is some good producers in that area, and a fair few Merino producers as well. It was something that I thought would get a bit of traction, and it did.”

Judges came from Darbys Falls and Boorowa to complete the judging as well as an associate judge from Warren.
Judging is conducted on each entrants property, the judges and interested spectators travelling from property to property through the Castlereagh region across the day.This is how judging is conducted across the state. Sometimes, the judges and interested spectators may travel together on a bus, but this inaugural Castlereagh event was by car.
The property of the first entrant was visited at 8am with the last property visited at 4pm.
The landholders run their maiden ewes to the sheepyards to be judged.
They are judged on how many sheep were classed out, how many
lambs were dropped and other factors such as, growth rates, structure, wool quality, evenness of the mob, and management.
“The judges look at the ewes in their own environment,” Mr Wilson said. “It’s designed so people can see the whole mob.”
This means that entrants cannot just select their best five or six sheep, they must enter a whole mob to be judged accordingly. The largest mob in this event featured 1250 merino ewes.
Mr Wilson also pointed to some of the qualities judges are looking for in a wide-ranging criteria: “Evenness throughout the mob, productivity, looking for sheep that suit the breeding objective of the entrant,” Mr Wilson said. “They are judged on wool quality, on carcass, and on structure.”




FUNDING NOW AVAILABLE
Applications for the next round of the SPARC Support Grant Program are now open and close Friday 18 April, with all applications to be submitted via SmartyGrants.
Fun Day in Victoria Park Dubbo is on Wednesday 16 April from 11am to 2pm with plenty of activities plus free food and refreshments.
The Wellington Family Fun Day will be held in Cameron Park on Thursday 17 April, from 11am - 2pm, with Pooka the clown making an appearance and lots more fun activities.
The SPARC Support Grant Program has $10,000 available to be shared between cultural programs, projects and events in the Dubbo region. More info at dubbo.nsw.gov.au/ CommunityGroups
PHOTOS BY COLIN ROUSE
Renae Day’s Family Day Care Kids joined Barnardo’s playgroup at Teamsters Park in Wellington on Thursday, March 13th. They shared a picnic morning tea together and played in the playground.







By DAVID DIXON
FURNITURE, tyres, and shopping trolleys, all-in-all, a full trailer of garbage, that was the fruits of the labours of Wellington’s Clean Up Australia Day in early March.
The event is an annual event organised by Emmalee Holmes and supported by the Wellington Community Progress and Action Group.
These committed local volunteers work together to highlight and address the priorities and interests of local residents, businesses, and not-for-profit community groups to make the district a better place to live in, work in, and visit, Ms Holmes explained.
“Within a short time-frame of less than two hours, an entire truckload of rubbish was collected, including furniture, tyres and shopping trolleys,” Ms Holmes revealed.
“This was the Progress Group’s sixth annual event, which means that six truckloads of rubbish have












munity, reserves, parks, streets, and rivers,” she added.
When it came to collecting waste, she explained, it was the same old locations that provided the most work for the crew.
“Once again, some of the worst hot-spots in Wellington, were within the Coles and Woolworths’ carparks, garden areas in the CBD,
“The rivers provide 70 per cent of our drinking water, so it is especially important to keep them clean and prevent litter and pollution from entering our waterways,” Ms Holmes argued.
Clean Up Australia Day is Australia’s largest community-based environmental event with more than 20 million Australians having


participated in their activities over the past 30 years.
This year, there were more than 10,000 Clean Up sites registered and 750,000 passionate Aussie volunteers who rolled-up their sleeves and got involved.
Today, Ms Holmes explained, the focus is as much on preventing rubbish entering the environment, as it is removing what has already ac-

cumulated, with Australia creating 2.5 million tonnes of plastic waste each year.
“Only 12 per cent of this is recycled, with the rest ending up in our parks, roadsides, bush, waterways, oceans or in landfill as rubbish,” Ms Holmes said.
“There are increasing pressures on our biodiversity, and an ever-growing volume of waste leaking into our natural and marine environments, so ‘Clean Up Australia Day’ is an opportunity to step-up for the environment, take collective action, and make a difference to the environment In our local area and ‘clean up our patch,” she concluded.
Thanks also went-out to the volunteers who participated as well as to the Clean Up Australia Day organisers for their support, and to Dubbo Regional Council staff for collecting and removing the rubbish after the event.


Thumbs up to the new roadworks completed along Tamworth Street over the past months. It’s a relief to see that last of those enormous potholes that use t open up, ready to gobble up my little car, after major storms – particularly at the TamworthDarling Street roundabout. And the road along the Tamworth Street shops and St Laurence’s area is also beautifully smooth to ride along.
Thumbs up to and a huge thank you to the ambos, rescue squad, firies, and Wilson Towing, who all came to my aid when I had an accident in east Dubbo on Christmas Eve. The ambulance officer was incredible, leaning in to a tight spot to treat and get me out. A big thanks again, I have recovered well.
Thumbs up to all the emergency services for their understanding, support, and skills when the chips are down. It is greatly appreciated.
Thumbs up to our local SES crews… keep up the good work!
Thumbs up to NRMA office staff plus roadside service: excellent service given.
Thumbs up to Telstra Orana Mall, you’re always very helpful.
Send your Thumbs Up via email to photos@dubbophotonews.com.au, mail to 5/33 Hawthorn Street, Dubbo NSW 2830, or phone 6885 4433.
Dubbo Photo News is a great local paper because people like you share your stories with us. If you have a story, event or news item, call us on 6885 4433 or email editor@dubbophotonews.com.au

By DAVID DIXON
INDIGENOUS business is now big bikkies worth billions of dollars to the Australian economy, with a special trade fair being held in Dubbo next week highlighting this new Aboriginal entrepreneurship.
Supply Nation – which works with Aboriginal and Torres Strait Islander businesses and procurement teams from government and corporate Australia to help support the Indigenous business sector – is hosting the Indigenous Businesses
Trade Fair next Wednesday, April 9 at the Dubbo Regional Theatre and Convention Centre.
“We are expecting around 60 exhibitors, and there is strong interest in the event which follows our very successful Perth event held in November last year; our Canberra Trade Fair, held on February 12, was sold-out with over 500 attendees,” a spokesperson for the event said.

Highlighting the new Aboriginal entrepreneurship, Supply Nation is hosting an Indigenous Businesses Trade Fair next Wednesday, April 9 at the Dubbo Regional Theatre and Convention Centre.
By HILDA NEWSTEAD
Members and guests started the New Year at Gilgandra Evening Branch’s CWA’s February Meeting enjoying north Asian culinary treats with some delicious Korean hors-d’oeuvres and beverages that were provided by the group’s International Officer, Helen Oats.
Awarding of badges to long-serving members also featured at the first meeting for 2025 with President Jess Reed welcoming the new year with promise of a range of interesting activities and events to look forward to.
In housekeeping news, branches were also reminded that the annual evaluation of safety in meeting places was due to be undertaken in March for the Gilgandra ladies, as well as the branch being selected to be audited. Acknowledgement was also made for the members who supported the Australia Day breakfast in late January.
In other news, the Show Committee are looking for volunteers to help at the Sydney Royal at the CWA Kiosk with accommodation provided for the week for





The Fair is another indicator of the boom in Indigenous businesses, they explained.
“We are a unique non-profit assisting the growth of Indigenous businesses through facilitating procurement form corporate, government and non-profit organisations,”” they added.
“In 2009/10 we facilitated $300,000 procurement spend into verified Indigenous businesses; we have just announced that the figure for 2023-24 is $4.6 billion,” the spokesperson said.
“We now have over 5500 verified businesses on our Indigenous Business Direct Database having commenced with 13 suppliers in 2009, with our member number is now over 820,” they concluded.
those scheduled to work. Also, jams and preserves are very welcome to sell at the Homebush event.
Branch reports were as follows:
HANDICRAFT: We still need many pin cushions to fill the box for the Handicraft display at the conference to be held in Wagga Wagga in 2025.
AGRICULTURE/ENVIRONMENT: A long and thorough discussion was held about the growing concerns with Telstra regarding reception. Madeline has spent many hours on her phone to speak to The Telstra team and NBN. It’s very obvious that this problem is wide-spread and has real repercussions on all businesses in the bush.
CULTURAL: A new year and lots of cultural events are planned for 2025 including: the local show, markets, the Gil Film weekend,and many more activities planned during the year.
INTERNATIONAL: Helen attended the CWA of NSW International weekend country of study for the Republic of Korea (commonly referred to as “South Korea” in Australia) after which our members enjoyed a wonderful
presentation
One of the over-arching philosophies of Korean society is the concept of “filial piety”. An example is respect for their elders, leaders, bosses, and other people in authority.
The Korean people also maintain that food and medicine share the same origin!
LAND COOKERY: Members are looking forward to many wonderful recipes, as well as more Facebook cooking videos to be released in 2025
MARKET REPORT: THE Gil Markets were a success and held the first week in February, though the CWA Banners were not displayed as they need to be repaired due to wind damage.
PUBLICITY: The CWA of NSW Publicity Forum will take over from the previous Wagga Daily publicity awards as of next year. The new State Publicity award will run from January–December and will be for entries received show-casing work during the 2025 calendar year with a presentation of a portfolio or collection of reports.
Option One: Electronic entries can
be posted on a USB or emailed to the Forum Convenor’s address as per the CWA directory.
Option Two: Written entries in a form of an A-4 portfolio of no more than 30 pages; ensure that no entries are submitted in a spiral band book.
Entries must be accompanied with the correct publicity form, from the procedure’s manual and post entries to CWA of NSW Head Office by March 1, 2026. All entries will be acknowledged upon receipt. Portfolio books must be accompanied with a self-addressed envelope for return mailing of your entry post-judging
First place Winner will be awarded the CWA of NSW Publicity medallion.
In other news, three CWA Gilgandra evening branch members celebrated a giant achievement after receiving their Long Service Badges at this meeting with President Jess making the presentation to: Julie Sawley, 36 years; Helen Oates, 27 years; and Hilda Newstead, 27 years.
This was a great way to finish the meeting, which was followed by supper.







This charming home is full of character and ideally situated in a peaceful yet convenient location, just a short distance from the river and within easy reach of the CBD. With a compact and private yard, it is well suited for first-home buyers or those looking to downsize. Featuring beautiful older-style details, the home embraces art deco influences in its well-presented kitchen and bathroom. High ceilings and cypress timber floorboards add warmth and charm, while a leafy front yard enhances privacy and tranquility. The location is a standout, offering a serene escape from the city’s hustle and bustle, with the river just a short walk away – perfect for a leisurely stroll or a relaxing paddle in a kayak.


Ready-built modern homes with a gated estate. The homes are ideally located in Manchurian Court, only moments from urban conveniences and Dubo’s CBD. Indulge in a relaxed, low maintenance lifestyle with pool, BBQ facility and Clubhouse. Representating affordable value from only $595,000, these are a must see.
38 Azure Ave, Dubbo












































































































Buying
Explore these options for securing homeownership without relying on conventional financing.
1. A rent-to-own agreement, also known as rent-to-buy, allows renters to make progress toward homeownership while living on the property. A portion of their monthly
rent is typically set aside as a credit toward a future down payment, allowing them to build equity over time.
2. A private lender can offer more flexibility if you have a lower credit score or can’t pay a large sum of money up front. However, be sure to carefully review the terms and interest rates associated with these loans, as well as the credentials and trustworthiness of the private lender.
3. Using cash to buy a home outright eliminates the need for a mortgage and any associated interest payments. This approach requires signifi-



cant savings but can provide a sense of financial freedom.
4. Leasing sometimes allows renters to live in a property with the potential to buy it

at a fixed price in the future. This arrangement can be a good option for individuals who need time to save for a deposit or work on improving their credit.
5. Owner financing, or vendor financing , is an arrangement by which the seller acts as the lender, financing the home purchase directly. Owner financing can offer more flexible terms than traditional mortgages, making it an attractive option for both the buyer and the seller.
Explore these alternative methods with a real estate agent in your area.

























Proudly sponsored by

Healthy Harold from Life Education conducted some tailored health and wellbeing programs with the students at Narromine Public School.
Each class visited the Life Education van and took part in the interactive modules.
The face-to-face lessons were also accompanied by a range of pre- and post-visit lessons to help extend and reinforce the learning which covered a range of topics across the three core areas of physical health, safety and social and emotional wellbeing.






































































Kaius
How old are you? 4
What are you good at? Jumping high.
What’s your favourite food? Yellow pasta. When you grow up, what do you think your job will be? Policeman.
What makes you laugh?
When Dad tickles me.
Who is your favourite character in a book? Knuckles.
How old are you when you stop being a kid? 14
If you could paint your bedroom, what colour would it be? Red.














































and





30 Decreased (8)
1 Sibilate (4) 2 Female killer (9) 3 Sifting implement (5)
4 Bunches (8)
6 Sedition (7)
7 Metal rod for stirring a fire (5)
8 Spoke to (9) 9 Cicatrice (4)
14 Reflects upon (9)
16 Cinnabar pigment (9)
Insert the missing letters to make 10 words – five reading across the
Place





























1. Which 1986 coming-of-age film is based on Stephen King’s novella The Body (1982)?
2. Psittacines are more commonly known as what animal?
3. Of the seven chakras, which one is located at the base of the spine?
4. The characters in Teenage Mutant Ninja Turtles are named after Italian Renaissance a) artists, b) musicians or c) philosophers?
5. What is the old Roman name for Scotland?
6. When Elle Fanning (pictured) made her film debut in I Am Sam, who played the older version of her character Lucy Dawson?
7. Which Roman emperor commissioned the wall across Northern Britain in 122 AD?
8. True or false: black bears are not always black?
9. In which country was the Battle of Waterloo fought?
10. Who played the titular king in both the 1951 Broadway production and 1956 film adaptation of The King and I?






TIP OF THE WEEK
ARIES: You’ll be rewarded for performing a remarkable deed, even if you see it as just lending a listening ear to someone in need. This simple act is heroic.
TAURUS: You’ll prioritise your family, home an d personal aspects of your life this week. You might even be motivated to start a family business from home.
GEMINI: Winter is fast approaching, and y ou ’re getting excited about all the adventures that await you. Well-deserved nature walks and social outings promise to be the highlights of the season.
by JoAnn Derson
I only buy my bread when it’s on a ‘two for one’ special. I freeze it in half loafs, so I always have fresh bread, even if my nest is empty now! – contributed by D.D.






CANCER: Be daring and embrace new adventures t h at could take you to all four corners of the globe. At work, a position you’ve always wanted will suddenly open up.
LEO: Dive deeper into your spirituality to achieve p er sonal fulfillment. If you commit to a cause, you may be able to face life’s big questions and discover a richer meaning in your life.
VIRGO: You’ll have a flood of ingenious ideas that w ill inspire you to create a masterpiece. You’ll be extremely generous with someone close to you.
LIBRA: You’ll be under a lot of pressure at work this w e ek. Take a moment to step back and recharge with
friends. Fortunately, you’ll organise an event that will bring together the people you cherish most.
SCORPIO: A revelation will light your way and guide y o u toward a career that aligns with your aspirations. You’ll face a learning process that will help you navigate and define your goals more clearly.
SAGITTARIUS: Let your dreams guide and inspire y ou as you plan your next vacation. Make sure you plan ahead to create memorable getaways with those you love.
CAPRICORN: You need to take a break and give y o urself permission to relax, especially if you’re feeling vulnerable. Going on a holiday could help you
work through diff icult emotions. This will allow you to return to work with a calmer mindset to tackle new challenges.
AQUARIUS: Negotiating with someone you have no emo t ional connection with is easier. Sometimes, you may be unwilling to be flexible when dealing with those closest to you.
PISCES: You may land an influential position at w o rk. Trust your instincts and organisational skills. They’ll help you if you’re aiming to score a top role within the company
this
















































“DBs”: from Rommel’s North Africa, to the 1970s schoolyards of Australia
By David Dixon
Often colloquially referred to as “DBs” –and must-have footwear for stylish Aussie teens from the 1950s to the 1990s – most people probably presumed that the name “desert boot” derived from the sandy tones of their suede uppers.
But that is only half-right. The desert boot was actually developed for Australian and British soldiers battling German Field Marshal Erwin Rommel’s famed Afrika Korps in Egypt, Libya, Morocco, and
Clark of the famed British shoe company, suede style of boot – known as “chukkas” –the South African veldskoen which became a popular footwear item in Southern Africa due to their robust and simple design. Clark then hit upon the idea of these becoming standard footwear for Commonwealth soldiers. Far cooler than the traditional heavy-duty Army leather boot, they were lightweight, tough, easy on feet having to tramp miles of desert dunes and gibber stones, with a crepe sole for

excellent footing.
Following their popularity during the war,
world with the debut of the Clarks’ Desert Boot at the 1949 Chicago Shoe Fair.
After feature coverage in Esquire
According to Clarks at their launch, inspiration came from “the crepe-soled, rough suede boots made in Cairo’s Khan el-Khalili bazaar for British Eighth Army

After the war they then became fashionable footwear for bohemians, artists, beatniks, hippies, and pop musicians worldwide.
m the ede s s, d w ide.



They also became the preferred protest boot for Australian high-schoolers, rebelling against the standard clunky black leather shoe that was the required uniform for almost all Australian schools up the turn of the century.





































Croquet: 8.15am, Muller Park Tennis and Croquet courts, Brisbane St, North Dubbo. New players of all ages are welcome. Tricia 0428 876 204 or Margaret 0427 018 946.
Dementia Sing Out Choir: Weekly 11am12.30pm, Generosity Church 51 Sheraton Road Dubbo. Contact Anne Gemmell 0481396404.
Ladies Luncheon: Will meet Saturday April 5 at Ingenia Gardens at 10 am for the Tradies Breakfast followed by our regular monthly lunch, 12 noon at the South Dubbo Tavern. Contact Bev on 68845401 by April 3, if interested. Parkrun - Dubbo: 8am every week, FREE timed (with barcode), 5km run, jog or walk, starts at Sandy Beach, dogs, prams are welcome. Email dubbohelpers@parkrun.com to help!
COMING
Car Boot Sale: Saturday, April 12, commences at 8am at St Brigid’s Car Park. Sausage sizzle, tea and coffee. More entries welcome. Contact Fran 0417 452 678 for enquiries.
CPSA Dubbo Meeting: Friday, April 11, 2025. 10am at the Dubbo RSL Club. Guest Speaker is from the police crime prevention unit. This is very important information for all seniors. All welcome, no charge. For further information, please contact 0427 251 121.
Rotary Club of Wellington: Wellington Rotary Dag Drags Sheep Dash, 13th April 2025, Gates open at 10am Wellington Showground. Gold Coin entry for Adults, Kids are Free ( but must be accompanied by an adult)
Contact Ian Parkes ( Event Chairperson) 0400 846 353
THURSDAY
Above Board Gamers: SECOND and FOURTH Thursday of the month, 6pm, Devil’s Hollow Brewery. Alan 0432 278 235 Akela Playgroup: 9.30am, Scout Hall, 4 Akela St., Sharna 0438 693 789
Badminton: 7.30pm-9.30pm, Delroy High School Auditorium, East Street, West Dubbo, $5 to play, $22 insurance ($20, school students).
Chris 6887 3413
Bingo - South Dubbo Veteran’s & Community Men’s Shed: 11am-12.30pm, West Dubbo Bowling Club. Barry 0439 344 349 Coffee, Craft and Chat: 9.30am-12pm, Gospel Hall, Cnr of Boundary Road and Taylor St. Anne 0428 425 958 Croquet: 8.15am for 8:30am start, Tuesday, Thursday. Croquet courts, Brisbane St, North Dubbo. Kate 0409 927 140, Lillian 0429 471 921 CWA Dubbo: FIRST Thursday of the month, 9.30am to 11am, Oaktree Retirement Village Peel Street, Dubbo. Marion 6884 2957
CWA Wongarbon Handicraft: SECOND Thursday of the month, Liz 0401 174 883. CWA Wongarbon: FIRST Thursday of the month, 10am, Wongarbon CWA rooms. Marjorie 6884 5558 Dubbo Anglican Church Trinity Kids Playgroup: 10am-12pm, Anglican Church Hall, 158 Brisbane St., during School terms. Contact 6884 4990 Dubbo Community Men’s Shed Inc: Mondays 9am to 1pm and Thu/Sat 1pm to 5pm. Small joining fee after three visits. All men are
welcome, Kevin 0427 253 445 Family History Society (Dubbo & District): 1pm to 4pm, volunteers on site during these hours, Western Plains Cultural Centre Community Arts Centre, Cnr Wingewarra and Gipps St Heart Support Walking Group: 12.30pm, (also Tuesdays), Ollie Robbins Oval, Cnr of Bligh Street. Supports gentle exercise promoting healthy hearts, Ray 0437 541 942
Let’s Walk together: 10am Thursdays weekly meet at Regand Park near the Walkway Bridge. Everyone is welcome. Supported by the Heart Foundation. Contact Jimmy at Connecting Community Services 1800 319 551.
Line Dancing: 9.30am to 12 noon, Greek Hall, corner Gipps and Roper Street, Dubbo. Kathy 6888 5287 or Lynn 6888 5263. Macquarie Masons Dubbo: SECOND Thursday of the month. All visitors are welcome, John O’Brien 0405 051 896. Outback Dragons Dubbo: 5.45pm (in summer), Sandy Beach amenities block. Come and try dragon boating, your first five paddles are Free. info@outbackdragons.com.au, Robyn 0427462504
Wellington Arts and Crafts: 10am-3pm, Small Hall in the Anglican Church grounds, Wellington, variety of crafts, activities and workshops offered. Dorothy 0408 601 066 Wellington Lions Preloved Book Fair: Wellington Lions Preloved Book Fair Thursday to Saturday 10am to 2pm, Western Gallery, corner Swift St and Mitchell Highway, Wellington. Preloved books, Jigsaw puzzles, Cds, Dvds and now board games with the money raised going to Charities that Club members choose.
FRIDAY
Alcoholics Anonymous Meetings: 7pm (1.5hrs) - ID meeting, Dubbo Community Health, Palmer Street, Dubbo. Contact Dee 0417 422 750, 1300 222 222 or www.aa.org.au. Central West Makers Place: 12pm-6pm, South Dubbo Veterans and Community Men’s Shed, Cnr Palmer and High Streets. 3D printing, robotics, pottery, and more. Adam 0431 038 866. Communion Service (Dubbo Anglican Church): 10am, Brotherhood House chapel, 158 Brisbane St.
Community Kitchen: FIRST Friday of the month, 6.30pm, Holy Trinity Hall, Brisbane St, free meal.
CPSA (Combined Pensioners and Superannuants Association): SECOND Friday each month, 10am, Dubbo RSL Club. Discuss issues, guest speaker. Further Information Barb 0427251121 Dubbo Nepalese Christian Fellowship: 6.30-8pm. Cyrel on 0416 826 701 or Kabita 0452 406 234.
Dubbo Parkinson’s Support Group: FIRST Friday of each month, 10.30am, Horizons village, Minore Road, Dubbo. Marsha Isbester 0427 373 842.
Lunchtime Prayer Group - Dubbo Anglican Church: 1-2pm in Brotherhood House, 158 Brisbane Street. Bring your lunch Narromine Food Barn: 9am-11am, Lowcost groceries and FREE fruit, vegetables and bread with any purchase to people in need. Ken Rumble on 0414 477 365 Spinning and Weaving: 10am, at Dubbo Arts
Send your community event info to diary@dubbophotonews.com.au or phone 6885 4433
and Craft Cottage, 137 Cobra Street. Anne 0408 891 225
Tai Chi at U3A: 10am, at the Community Arts Centre, Western Plains Cultural Centre, 76 Wingewarra Street. Richard 6888 5656
Urban Tribe: 2pm, with dancing, music, singing, caring and sharing. 0459 762 702
Wellington Lions Preloved Book Fair: Wellington Lions Preloved Book Fair Thursday to Saturday 10am to 2pm, Western Gallery, corner Swift St and Mitchell Highway, Wellington. Preloved books, Jigsaw puzzles, Cds, DVDs and now board games with the money raised going to Charities that Club members choose.
Western Plains Trefoil Guild: SECOND Friday of each month, 10.30am, Orana Gardens Round house. Please confirm the meeting will be on. Dorothy 6884 6646
Beekeepers Inc - Orana: SECOND Saturday of the month, 9.15am, Narromine Tennis Club rooms, unless other arrangements are made. orana.secretary@beekeepers.asn.au
Bridge Club - Dubbo: 1pm until approximately 4.30pm, Bultje Street. $7 members, $9 non-members. Libby 0428 254 324.
Croquet: 8.15am, Muller Park Tennis and Croquet courts, Brisbane St, North Dubbo. New players of all ages are welcome. Tricia 0428 876 204 or Margaret 0427 018 946.
CWA Gilgandra Market: FIRST Saturday of the month, 9am-1pm, Cakes, fruit, pickles, plants and more! New stall holders are welcome. $5 per table, proceeds to CWA. Contact Hilda 0427471270.
Dubbo Anglican Church Vigil Communion Service: 6pm, 158 Brisbane Street. Contact 6884 4990
Dubbo Bridge Club: 1pm, Bultje Street (Tennis Courts), Dubbo. $7 members, $9 non-members. Libby 0428 254 324
Dubbo Community Men’s Shed Inc: Mondays, 9am to 1pm and Thu/Sat 1pm to 5pm. Small joining fee after three visits. “All men are welcome.” Kevin 0427 253 445
Dubbo Slot Car Racing Club: FIRST and THIRD Saturday of the month, 4pm, Seniors (15+), old Scouts Building, 189-191 Talbragar Street, across from Aldi. Terry 0408 260 965. Embroiderers - Dubbo: 10:00am- 3:00 pm (also see Tuesday listing) All are welcome Macquarie Regional Library
Contact Patricia 0439846400
Family History Society (Dubbo & District): 10am to 1pm, volunteers on site during these hours, Western Plains Cultural Centre Community Arts Centre, Cnr Wingewarra and Gipps St.
Orana Writers’ Hub: 1st Saturday of the month 10-1. Music Room WPCC
Patchwork and Quilters Group: 9am, SECOND and LAST Saturday of the month, Dubbo Pipe Band Hall, Cnr Darling and Wingewarra Sts. Charlene on 0408 825 180 Parkrun - Dubbo: 8am every week, FREE timed (with barcode), 5km run, jog or walk, starts at Sandy Beach, dogs, prams are welcome. Email dubbohelpers@parkrun.com to help!
RSL Tennis Club: 12.30pm, Paramount Tennis Club courts for enjoyable social tennis. All welcome 0437824743
Diary entries need to be 40 words or less, and are only for not-for-profit community groups . Placement will be at the editor’s discretion and subject to space availability – because Diary listings are free! Please include your daytime phone number and/or address when submitting details. Entries close 10am Tuesday for that Thursday’s edition.
Saturday Art: 10am, at Dubbo Arts and Crafts Society Cottage, 137 Cobra St. Pam 6885 1918. Seventh-day Adventist Church Bible Study: 9.30am, Sabbath School and children’s/ youth Sabbath School, 11am, Divine Service. Cnr Cobra and Sterling Sts. dubbo.adventist.org.au
Talbragar CWA: First Saturday of the Month. 45 L Boothenba Road, Dubbo commencing at 2pm. Will be 90 this year! Contact Ronda on 0419 275 223.
Transition Dubbo Food + Film Night: For information about future events, contact to Peter 0439 091 767
Wellington Lions Preloved Book Fair: Wellington Lions Preloved Book Fair Thursday to Saturday 10am to 2pm, Western Gallery, corner Swift St and Mitchell Highway, Wellington. Preloved books, Jigsaw puzzles, Cds, Dvds and now board games with the money raised going to Charities that Club members choose.
Alcoholics Anonymous Meetings (Steps and Traditions): 7pm (1.5hrs), ‘Steps and Traditions’ meeting, Dubbo Community Health, Palmer St. Jack 0418 605 041, Sally 0427 829 807, 1300 222 222 or www.aa.org.au
Australian Kite Flyers Society: SECOND Sunday of the month, 10am, Jubilee Oval. See how to build and fly modern (and old) kites.
David 0476 223 342
Bicycle User Group Social Ride: 9am, at Wahroonga Park. Mick 0437 136 169 or Sam 0429826076, dubbobug.org.au
Dubbo Acoustic Musicjam (DAMjam): SECOND Sunday of the month, 2pm to 5pm, Milestone Hotel, upstairs. Join acoustic sessions or just listen. Peter 0457 787 143
Dubbo Anglican Church Traditional Communion Service: 8am, 158 Brisbane Street. 6884 4990
Dubbo Anglican Church: 10am, Trinity Kids Sunday School and family Communion service. Dubbo Baptist Church: 6pm, at 251 Cobra Street (next to Spotlight), during school terms. Come along and discover if church is still relevant in today’s world. Everyone is welcome. 6884 2320
Dubbo Baptist Church: 9.30am, 251 Cobra Street (next to Spotlight). Everyone is welcome. 6884 2320
Dubbo Pistol Club: 12.30pm, 143L Old Dubbo Road, 6882 0007
Orana K9 Training Club INC: New intake class every 7th Sunday starting 4/2/24.. ( daylight savings start time 8.45am Eastern Standard time 9.45am ). Orana K9 Training are now training at Pioneer Oval Howard Ave West Dubbo. Contact Reg 0428849877 or Dianne 0429847380.
Orana Pistol Club: 9am, Hyandra Lane, Dubbo. Sundays only, 6887 3704
The Write In: An opportunity for writers to sit in writerly companionship, writing. 3rd Sunday of the month. Dubbo library meeting room from 11.30.
Traditional Catholic Latin Mass –Rawsonville: SECOND Sunday of the month, 9am, Rawsonville Soldier’s Memorial Hall, Rawsonville Road. 0429 920 842
Transcendental Meditation (TM): Free introductory talks via www.tm.org.au. Maharishi Foundation Australia scientifically proven ben-
efits of TM. Contact David 0424 252 834
MONDAY
Alcoholics Anonymous (Daily Reflections Meeting): 12pm Monday Lunch (1.5hr) – ‘Daily Reflections’ meeting St Brigid’s Catholic Church meeting rooms, 198 Brisbane St, Dubbo. Please contact David 0417 063 087 or contact 1300 222 222 or www.aa.org.au.
Amnesty International Dubbo: SECOND Monday of the month, 5.30pm-6.30pm, St Brigid’s meeting room. Contact Sandra Lindeman amnesty.dubbo@gmail.com or 0419 167 574.
Anglican Women’s Association: 5.30pm, at Holy Trinity. Dorothy 6884 4990.
Australian Air Force Cadets 313 “City of Dubbo” Squadron: 6pm-9.30pm, Army Barracks (Cnr Kokoda Pl and Wingewarra St). NOW recruiting, 13 to 18 years, rewarding activities.
Dubbo Bridge Club: FOURTH Monday of the month, 10am-1pm, Bultje Street. $7 members, $9 non-members. Libby 0428 254 324.
Dubbo City Physical Culture Club: 4.30pm start, Wesley Community Hall, 66 Church St. Fun, affordable dance for girls/ladies, 4yrs and up, all fitness levels. dubbocityphysie@live.com. au
Dubbo Community Men’s Shed Inc: Mondays, 9am to 1pm and Thu/Sat 1pm to 5pm. Small joining fee after three visits. “All men are welcome.” Kevin 0427 253 445.
Dubbo Multicultural Women’s Group: THIRD Monday of the month, 10am, St Brigid’s Meeting Room in Brisbane Street. Women of all backgrounds are invited. 1800 319 551.
Narromine Community Women’s Shed: 10am -3pm, (also Wednesdays), The Wesley Centre, 138 Dandaloo Street, Narromine. Leona 0487 200 987
Patchwork: 10am-3pm, at Dubbo Arts & Craft Cottage, 137 Cobra St, June 6882 4677. RFDS Dubbo Support Group monthly meetings: FIRST Monday of the month, RFDS Visitor Experience, 5pm, 21 Judy Jakins Drive, Dubbo Airport. Jeanette Hamilton 0429 673 366. Rotary Club of Dubbo: 6pm-8pm, Westside Hotel, Whylandra Street, West Dubbo. Contact Lyn Wicks, 0428 342 374, Carla Pittman, 0418 294 438 or dubborotaryclub@hotmail.com
Sing Australia Dubbo Choir: 6pm-8pm, Bridge Club, Bultje Street. NO auditions, no requirements to read music and no singing experience necessary. Contact Michele Peak 0428 680 775.
Tai Chi 10 Form: 2.30pm-3.30pm during school terms at U3A, Community Arts Centre, WPCC, 76 Wingewarra St.. Laney 6882 4680 or laneyluk@gmail.com.
TUESDAY
Aboriginal Elders Walkabout Ministry Group: 9.30am - 2pm in Holy Trinity Church Hall, 158 Brisbane Street Croquet: 8.15am for 8:30am start, Tuesday, Thursday. Croquet courts, Brisbane St, North Dubbo. Kate 0409 927 140, Lillian 0429 471 921 Dementia Sing Out Choir: Weekly 11am12.30pm, Generosity Church 51 Sheraton Road Dubbo. Contact Anne Gemmell 0481396404. Depression Recovery Group: 10.30am, at
the Catholic Parish Meeting Room, Brisbane St. Norm 6882 6081 or Sandra 0432 647 877 Dubbo Camera Club: Meet 1st Tuesday of the Month at Club Dubbo at 7pm. Everyone is welcome to join. See F.B. page for more details. Dubbo City Physical Culture Club: 5pm start, Holy Trinity Hall, Brisbane Street, Dubbo. Fun, affordable dance for girls/ladies, 4yrs and up, all fitness levels. dubbocityphysie@live.com. au Dubbo Chess Club: 7pm-9pm, at Dubbo RSL. Juniors welcome. Trevor 0424 225 323 and Babu 0422 877 165
Dubbo City Ladies Probus Club: Meet on the second Tuesday of each month in the Masonic Village Hall, Darby Close at 10am contact Marie Francis 0408845640. Dubbo Embroiderers: 9:30am- 3:00pm SECOND and FOURTH Tuesday of the month (also see Saturday listing) Dubbo Bridge Club, Elston Park, Bultje St Dubbo. All are welcome. Contact Patricia 0439846400
Dubbo Lions Club Inc: FIRST and THIRD Tuesday of the month, 6.30pm, Club Dubbo. PO Box 285 Dubbo, Lois on 0428288325 or dubbolionsinc@gmail.com.
Dubbo Men’s Probus: FIRST Tuesday of every month, 11am, Masonic Hall, Bob Ellis 0428217752
Dubbo Prostate Support Group: For information about future meetings, Elizabeth 0408 682 968
Dubbo RSL Euchre Club: 7pm, for 7.30pm, Dubbo RSL, Glen 0419 179 985 or Doreen 6882 6163
Family History Society (Dubbo & District): 1pm to 4pm, Cnr Wingewarra & Gipps Sts, Western Plains Cultural Centre, Community Arts Centre.
Girls Brigade: During school term, 6pm to 8pm, Orana Baptist Church, 4 Palmer St. For all school aged girls. Enjoy crafts, games, camps, stories, songs, cooking and much more. Julie 0428 821 829
Heart Support Walking Group: 12.30pm, (also Thursday), Ollie Robbins Oval, Cnr of Bligh Street. Supports gentle exercise promoting healthy hearts, contact Ray 0437 541 942

Orana Physical Culture: 4pm onwards, starts with 2-4 years Sparkles class, Auditorium at St Mary’s Primary School. See the Orana Physical Culture Facebook page Rotary Club of Dubbo Macquarie: 12.30pm - 2pm, Westside Hotel, contact Peter McInnes 0417 140 149 Rotary Club of Dubbo South: 6pm, at South Dubbo Tavern Silver Craft: THIRD Tuesday of the month, 10am, at Dubbo Arts and Crafts Society Cottage, 137 Cobra St. Julie 6884 4919 Smart Recovery (Behaviour Change Support Group): 5pm, online or in person. Rob on 0417 497 187 Spinning Group: Every third Tuesday 10am -4pm Dubbo Art and Craft Cottage, 137 Cobra Street. Contact Julie 0418 976 663 South Dubbo Veteran’s & Community Men’s Shed: 9am-12pm, Cnr of High and Palmer Streets. New members welcome Reach Out & Discussion Group for people with Eating Disorders Expressions of Interest: Tuesdays. Venue TBA. Ph: 0455255137 after rCulture








































midday to express interest.
Toastmasters Club: FIRST and THIRD Tuesday of the month, 7pm9pm, Dubbo RSL Club, Brisbane St., Sharon Allan 0408 156 015 or email sallan@rhdubbo.com.au
Women’s Wellbeing Walking Group: 10am Tuesdays fortnightly meeting at Victoria Park BBQ area. 22nd Oct, 5th Nov, 19th Nov. Women of all ages welcome. Kathryn at Connecting Community Services 1800 319 551.
WEDNESDAY
Akela Playgroup: (also see Thursday listing), 10.30am, Scout Hall, 4 Akela Street, Sharna 0438 693 789.
Alcoholics Anonymous Dubbo: Meet Wednesday 7pm (1.5hr) – ‘Topic‘ meeting St Brigid’s Catholic Church meeting rooms, 198 Brisbane St, Dubbo Please contact Ian 0447 176 590 Or contact 1300 222 222 or www.aa.org. au for info on meetings.
Ballroom Dancing: Wednesday
7:30-9:30pm $10. Wesley Hall Cnr of Carrington Avenue & Church Street, Dubbo. Graham Woods 0447 885 603
Blood Cancer Support Group: FIRST Wednesday of month, 10.30am-12pm, Venue changes each month. Louise or Emma 0412 706 785
Breast Cancer Support Group: FOURTH Wednesday of every month, 10am, Baptist Church, Palmer Street, Community Health 5853 2545
Bric-a-brac sale, weekly - South Dubbo Veterans and Community Men’s Shed: 10am-12pm, Corner of Palmer and High Streets. Contact Barry on 0439 344 349
Cake Cupper & Cancer Support Group: SECOND Wednesday of month,
2:30-4pm, Western Cancer Centre Dubbo, carer is also welcome. For patients having current cancer treatment. Megs or Fi 6809 6200
Coffee, Craft & Chat: FORTNIGHTLY, 10am-12pm, Gospel Chapel on Boundary Road. Anne 0428 425 958
CWA Dubbo Evening Branch:
THIRD Wednesday of the month, 6:00pm, 3 Frith Street. Contact Barb on 0409 159 556.
CWA Narromine: SECOND Wednesday of the month, 5.30pm, USMC. Carolyn 0427747478
CWA Terramungamine: SECOND Wednesday of the month, 10am, Dubbo RSL Club. Barb 0427 251 121
CWA Wellington Branch: Second Wednesday of Month, 10:30 a.m., Wellington CWA Rooms, Warne St, Wellington. Contact Marion on 0429033836
Dementia Friendship Group: SECOND Wednesday of month, 10:30am, Western Plains Cultural Centre, Creo Cafe, Wingewarra St. Anne Gemmell 0481396404. Dubbo Arts and Craft Cottage: 10am-4pm, 137 Cobra Street. A large range of handcrafted gifts made by members available. Contact 6881 6410 Dubbo and District Family History Society event: Linda Barnes will show you how to begin discovering your family history. Four weeks, Wednesdays March 6, 13, 20 and 27. 10.30am to
12.30pm at Community Arts Centre
$7.50 per session for DDFHS members, $15 for non-members. To reserve your place phone Linda on 68878284 or email martinandlinda@gmail.com
Dubbo Bobbin Lacemakers: THIRD Wednesday of the month, 10am-3pm, Arts & Crafts Society Cottage and Craft Shop, 137 Cobra Street. Judy 6882 5776
Dubbo Bridge Club: 9.45am, for 10am-1pm, Bultje Street (Tennis Courts), Dubbo. $7 members, $9 non-members. Libby 0428 254 324
Dubbo Community Garden: 9am12pm, 4 Palmer Street. A time to garden with others, learn more skills and grow friendships. Contact Denise 0433 623 842 or Julie 0428 821 829
Dubbo Electric Vehicle Interest, Owners, Users & Supporters (DEVIOUS) group: FIRST Wednesday of each month, 12:30pm to 1:30pm, Western Plains Cultural Centre café. Chris 0409 321 470
Dubbo Garden Club: 10am, FIRST Wednesday of month, Garden gatherings with morning tea. Contact, President, Annette Storer, 0429 828 882
Dundullimal Dubbo Support Crew Inc: FOURTH Wednesday of month, 10am, Dundullimal Homestead. Support Homestead functions. 6884 9984, dundullimal@nationaltrust.com. au
Gamblers Anonymous: 6pm, Baptist Church, Dubbo. Victor 0407 799 139
Geurie Craft Group: 9am-2pm, Geurie Bowling Club. Everyone is welcome. Contact Colene 0400422335
Line Dancing: 6.30pm to 8:30pm, Greek Hall, corner Gipps and Roper Street, Dubbo. Kathy 6888 5287 or Lynn 6888 5263.
Lodge Allan Stuart 416: SECOND Wednesday of month, Geurie Masonic Centre. Please email secretary@lodgeallanstuart416.org.au
Macquarie Intermediate Band: 6pm, school term, Band Hall, Boundary Rd. 6884 6686/info@macqcon.org.au, Dubbo District Band 0422 194 059 dubboband@gmail.com
Narromine Community Women’s Shed: Mondays and Wednesdays, 10am -3pm, The Wesley Centre, 138 Dandaloo Street, Narromine. Leona 0487 200 987
Survivors Of Suicide Bereavement Group: Wednesdays, by expressions of interest. Please contact 0455 255 137 after midday.
Walter T. Grant Seniors Social Club: 9am-2pm, Scout’s Hall, Welchman Street. $10 per day. BYO lunch. Pre-lunch cards and games, post-lunch bingo. Jan Miller 0418 255 217 West Dubbo Rotary: 6pm, Club Dubbo, Whylandra Street West Dubbo Zumba Kids: 4.15pm, West Dubbo Primary Community Centre. A FUN dynamic class that keeps young bodies active, for kids aged 5 to 12. Gold coin donation per family.





Contribute
Emily Ricki Mae Riley
Born 27/02/2025
Weight 3370g
Parents Ryan and Zoe Riley of Dubbo

Siblings Georgia and Layton Grandparents Rick and Margo Agnew, Kathy Ryan

Remmi Jane Olive Wyatt
Born 1/8/2024

ight 2200g

Parent Tahnee Jane Wyatt and Jamie

Alan Wyatt of Dubbo

Oskah Wyatt (23 months)
Tony Mann of Narromine, Corrine Prest of Narara, Rodney and Julie Wyatt of


Ruth France Bartimote
Born 26/3/2025
Weight 4500g
Parents Tim and Eve Bartimote of of Dubbo





Siblings Mirana (5) and Jeminah (2) Mirana Grandparents Sue and Scott Hosking (Warren), Mark and Christine Bartimote

Great Grandparents (Dubbo), Laurence and Jillian Edwards (Sydney)

g te (Syd
















Building Strong,
•Wellington Correctional Centre
•Full-time

















































recently hosted visitors from the
and
Stars Pickleballers at the Big Chill Pickleball tournament. PHOTOS: CONTRIBUTED
LOOKING like a fun amalgam of tennis and badminton, the increasing popularity of “pickleball” locally, has been reflected in recent representative success for the sport in the region.
“In what is a further indication of the level of ‘Pickleballer’ quality at the Dubbo Pickleball Centre, Deb Crisante and Dale Wallace travelled to Canberra representing the Western Stars Pickleballers at the Big Chill Pickleball tournament recent-
ly,” a Spokesperson revealed.
“This saw them collect silver in the 0–50s Division, a huge effort, adding more medals to the ever-increasing number,” they added.
Dale then followed this up by collecting a Bronze in the Men’s Over 50s singles; a fantastic effort!
“Following-on from those individual achievements, the Club hosted visitors from the Orange PCYC pickleball club
Contributed by DUBBO RSL BOWLS
GOOD roll-up at the Combination Bowls on Sunday involved a total of 43 bowlers enjoying the morning’s competition.
In results, Rink 13 took-out the first place with Ken Whittaker, Eric Satchell, and Peter Sinclair beating the usually-consistent Tracey Keenan, Steve Evans, and Steve Kelly by 29-3.
Chris Castlehouse, Robert Edwards, and Phil Knight on Rink 14 took-out second place from Alan Andriske, Ruby Stockings, and Ros Joseph by 21-3.
The ever “Lucky” Leo Balstead on Rink Seven played as “swinger” to both teams again this week, taking third place with Jenny Spratt and Brian Jones from
and a few players from Armidale Pickleball.
‘All up, some 50 odd players contested more than 60 games across the courts over four hours of play on Saturday,” the spokesperson said “What a day, great sportsmanship, great competition and great fun, a day that ended with the Orange ballers snatching the Pickle Cup from the Stars, there will be revenge in the future,” they concluded.
Daphne Dunbar and Paul Goodstat bowling 24-9.
A very small margin of one shot separated the pairs played by Gaye Cottee and Gordon Scott, winning Rink Eight from Vicki Hummell and Brett Miller by 17-16. On Rink Nine, another set of pairs were played with Gordon Lumis and Mike Twohill defeating Ray Stawhan and Bryan O’Sullivan by 22-9.
Mary Perry, John Zeb, and Graham Ross, played on Rink 10 and beat Ron McCauley, Therese Gaio, and Matt Quill by 18-14.
Averall Cox, Cheryl Storch, and Col Cottee also took Rink 11 by a razor-thin 19-18 from Sue McCauley, Garry Huggins, and Mick Strawhan, On Rink 12, Dick Whiteford,
USING a small paddle and modified wiffle orb (a perforated hollow polymer ball), Pickleball is played on a court either indoors or outdoors, that is the same size as a badminton doubles court. The scoring is different to tennis with most matches decided by being the first player or team to reach 11 points, with a lead

It was invented in 1965 as a children’s backyard game in the United States on Bainbridge Island near Seattle in Washington; the state on America’s north-west coast, not the nation’s capital city, Washington DC. In honour of its increasingly worldwide popularity, Pickleball was named the official state sport of

Shirley Marchant, and Col Dover won by 18-10 from Sue Armstrong Frank Armstrong, and Todd O’Dea with only one “rester” this week, won by Gaye
Players Note: There will be no Combination bowls on Sunday, April 13, due to
at the Sporties. As always, new and casual players are welcome and can call 0419 248 520 for more information. Players names must be in by 9am for a 9.30 start.
By GEOFF MANN
MIKE Alborough was farewelled last week, a man of great character, community service, and a loud voice for the Rhinos Rugby Club.
I had the privilege of spending time in the middle of cricket fields umpiring, at night cricket and on Saturday afternoons commentating and chatting about his great sporting loves.
Sons Jason and Stephen and their mother, Maria paid tribute at St Lawrence’s alongside family, including a growing cohort of grandchildren; their late brother James was remembered fondly in Jason’s eulogy.
Mike was a larger-than-life character who retired after decades of true public service, including his last engagement as Regional Manager of the State Emergency Service.
He was an ebullient person, always the first with a smile and a big hand-out to greet you. Known for his repartee on all topics, Jason began his words of tribute this way:
Contributed By CLUB DUBBO
STATE CHAMPIONSHIPS
West Dubbo bowlers have been well-represented at the Bowls NSW State Championships held in Ballina and surrounds over last week and the coming week.
Bowls’ Manager, Anthony Brown, reached the quarter-finals in both the All Abilities Singles and Pairs Championships.
In the Mixed Pairs, Liam Morrow and Dubbo City’s Michelle Harkin narrowly missed out on a quarter-final berth, winning one and just going down in the other two games in their sectional play-offs.
Steve Ryan, Jarrod Palmer, and Lloyd Peirce are currently playing in the Open Reserve Triples, while, next week, Tracey Silk, Ros Gilholme, Deb Morrow, and Judy Cassidy will compete in the Ladies Fours Championship.
“To honour my father, I would be doing a disservice if I was to keep this brief. So please bear with me while I try and wrap-up in five or so minutes a 78year life of a great father, husband and communicator – that is, a person who loved to chat!”
Mike was born in London in 1946 and came to Australia with his family as a ‘£10 Pom’.
When he was two, he was the eldest of three including sisters Marilyn and Vicki, he grew-up in Merrylands in Sydney’s western suburbs.
He was always involved in sport, particularly football, swimming and cricket and entered fully into whatever community in

“Dad was fair, unwaveringly honest, and such a stickler for rules or the law. We knew he was always trying to protect us and keep us from harm,” he added.
Mike and Marie met in Dubbo when he was 21 and working with the Lands Department. It took 12 months for their romance to blossom: “as Mum thought he was a big city upstart!”
Jason told us Mike and Maria married in 1969 and: “For their honeymoon, Dad took-up a job in Moree!”
Mike continued his career that had started at the State Brickworks in 1967 with stints with the Lands Department at Dubbo, Moree, Sydney, Tamworth, back to Moree and then with the Education Dept in Wollongong.

bo in 1983, it was as the TAFE Student Education Officer until he was appointed SES Divisional Executive Officer in 1987, a role he maintained until retirement in Along the way, Mike threw
himself into community service through Lions and Apex, was part of swimming clubs in Moree, Wollongong, and Tamworth and was a founding father of Swimtech here in Dubbo. He was also heavily involved with cricket and rugby, at South Dubbo and the Rhinos.
Mike was awarded Life Membership of his beloved “world’s biggest animals, The Dubbo Rhinos”, for his efforts in promoting the club through many difficult times as they worked hard to establish themselves in the strong Central West Rugby competition. In latter years, Mike was a valued and hard-working counsellor with Lifeline and a valued contributor to St Vincent de Paul.
One of his proudest honours was
CLUB CHAMPIONSHIPS
Rain prevented play in last Saturday’s Men’s and Women’s Triples Championships. Nominations for the Men’s and Women’s Club Fours Championships are now on the noticeboard. Players need to check the noticeboard for full details.

autumn season will be held tomorrow (Friday) evening, beginning at 5.30 and concluding at 6.30. This FUN program, for girls and boys aged between 8–14 years is managed by the qualified club coaches and includes a kids’ meal at the end of each session.
For more information, contact effervescent Club Dubbo Bowls’ Manager, Anthony Brown, on 0403 401 567.
SOCIAL BOWLS
John Zeb, Jill Parker (from
was the team of John Cole, John Mackenzie, and Mick Strawhan, whilst third spot, on a countback, went to Frank Bartlett, Jess Gibson, and Steve Ryan. In the March attendance draw, $50 each was taken-out by Bev Goss and John Mackenzie. Bev Margery was also a big money winner, when her number came out in the Lucky Draw.
On Friday, Frank Bartlett, Warren Brown, and John Davis were
to the fore, easily accounting for the opposition across No. 2 Green. A distant second was the team comprising Tony Leonard, John Zeb, and Graham Ross. Max Low had plenty to smile about when he took home the Lucky Draw cash.

Last Sunday, a good field kicked-off the morning’s social bowls. The winners were John Fardell and Lindsay Burden, with Gai Morrison and Leanne Erwin worthy runners-up. ‘Fardy’s’ day was enhanced even further when he made off with the Lucky Draw money.
draw is up to $5500, whilst Friday’s badge draw stands at $5000. COMING UP
Events coming-up, include the $10 000 Easter Open Pairs Tournament being held on Friday and Saturday, April 18–19.
Thought for the Week: “The future depends on what we do in the present.” (Mahatma Gandhi)




Major Dubbo hockey representative event, Masters in the Bush, was another roaring success featuring three days of hockey, fun, laughter, and heat, Australian Masters representative, Tracey Hardie-Jones enthused.
“We started-off early Friday morning at 7am with teams from all over Australia, games went all day until 7.30pm, and that’s when the fun began with the annual dinner with the theme of the night being, ‘Abba’,” Tracey revealed.
“Saturday morning, the games started at 7am again, with a few tired heads; the hockey was of very high standard with lots of high-level skills demonstrated,” she added.
With the weather remaining unseasonably hot with temperatures in the high 30s, this didn’t stop the will to win.
“The annual ‘Dash Cash’, sponsored by Devils hollow was also a smash hit, with three age groups and three worthy winners,” Tracey said.
“Teams made the best of their accommodation between games cooling off in the pools and visiting our tourist attractions and our local restaurants,” she explained.
Sunday saw the last round games before the pressures was on for the finals, Tracey said.
“We had three divisions with Parkes taking-out the First Division, with ‘Buzzards’ from Sydney and ‘G-Force’ of the ACT the joint premiers of Second Division, with the ‘Devils’ the third Division winners,” Tracey concluded.




















By BRYSON LUFF
BARADINE Sportsground is the venue for the much-anticipated kick-off for the 2025 Christie and Hood Castlereagh League season, with the Magpies hosting the annual League Tag Knockout on Saturday, April 5.
All 10 clubs in this year’s comp will be in action with the first blockbuster involving the home team up against last year’s grand
finalists, the Coolah Kangaroos from 11am. This match should create a lot of interest and set the scene for what will be a jampacked day of action, with 14 games to be played culminating with the final which will commence at 3.40pm.
Warren Bulldogs, in what is their comeback season after an absence of some seven years, will have their first official Castlereagh League outing against Coonamble
By GEOFF MANN
DUBBO Macquarie Raiders are hoping they can emulate the 1975 Blues team and take-out the Peter McDonald Premiership after winning at Blayney on Saturday.
The latest team is certainly off to a good start, winning all their matches before tak-
ing the final easily by 16-8 over Group 10 heavyweights, Bathurst Panthers.
Macquarie is celebrating their 1975 win on the June Long weekend, while the 1985 Under 18s and First Grade will also get-together in May to relive their dual premierships played on a very wet day at the Showground.
at 12 midday.
Narromine Jets will also start their 2024 premiership defence, when they take the field at 12.20pm, lining up against the Gulgong Terriers, hoping to repeat their effort from last year when they commenced their winning campaign by taking home the knockout shield.
Castlereagh League Chairman, Chris Deighton, indicated that it was good to get the 2025 season
underway.
“It looks like another great year for the Castlereagh competition, and it is always great to see the knockouts roll around each year because they signal that the kickoff to the competition proper is not far away,” Mr Deighton said.
In fact, the first round of the competition is set down for Saturday, April 26, but the knockout action will continue on Saturday, April 12, when Warren’s Victo-
ria Oval will be the venue for the Christie and Hood Castlereagh League senior rugby league knockout.
There will be no action over the Easter break!
Meanwhile, the Gilgandra Panthers have reported improved player attendance at training after a positive session on Tuesday, March 25 with good numbers.




By GEORGE CLARKE
COACH Ivan Cleary believes Isaah Yeo will be remembered as one of rugby league’s greatest forwards as Penrith look to use their co-captain’s milestone match to show who “the real Panthers are".
After a sluggish (1-3) start to 2025, Cleary confirmed on Monday that halfback Nathan Cleary (concussion) will be back to face North Queensland on Friday at CommBank Stadium in Yeo’s 250th NRL match.
But the inclusion of the four-time premiership winning No. 7 is offset by the fact that metre-eating winger Brian To’o will be absent for up to a month with a hamstring injury.
To’o’s absence likely opens the door for Casey McLean with fullback Dylan Edwards rated touch and go to return from a groin strain.
To’o came off late in last week’s 28-18 loss to South Sydney which represented the first
time since 2019 that the Panthers have lost three-straight NRL games.
“If I could change it, I would have three wins but that’s our reality at the moment,” Yeo said.
Yeo, 30, is one of the few survivors of Penrith’s 2019 campaign where a 10th placed finish is widely seen as the springboard to the club’s unrivalled success in the NRL era.
One of the most influential changes the Panthers made in 2020 – when they won the minor premiership and fell to Melbourne in the grand final – was to shift Yeo to lock.
After beginning his NRL career as a skinny outside back from Dubbo and becoming an edge forward, Yeo really found his calling as a ball-playing No. 13 at the start of the NRL’s six-again era.
“Thank, Christ, they moved me to lock,” Yeo said.
“I’ve been around some wonderful coaches and staff who have helped me el-
evate my game.
“Ivan moved me to lock fulltime and Trent Barrett was the attack coach when I first moved into that position and he helped me a tremendous amount.
“After 2019 – that was a disappointing season – it could have gone either way there, but they trusted me and I like to think I’ve repaid a bit of that.” Cleary said his lock, who has blossomed into a regular for the NSW State of Origin side, co-captained Penrith to four titles and skippered Australia deserved to be seen “as one of the best forwards in the game that’s ever played".
“He’s the current Golden Boot winner,” Cleary said.
“If you have a look at the past winners, that says a fair bit about where he is.
“He’d be the first to admit that as an edge player, he was certainly capable but didn’t have certain skill sets that fit an elite back-rower.
“It turns out that what he can do in the middle goes beyond what a lot of other people can do, so it’s been a good move for him and he’s made it his own.” Cleary remains upbeat about the Panthers’ fortunes despite the club’s personnel issues and the fact their defensive output has been way down on previous years.
Penrith conceded an average of 29.5 points through the opening four rounds.
From the start of the 2020 campaign to the end of last season when they claimed their fourth-straight premiership, the Panthers’ stubborn defence leaked a measly 13 points per game.
“The other night (against Souths) I felt like there were parts to our game where regardless of who’s on the field – there was a big difference between the first half and the second half.” Cleary said.
“If we can get the balance we’ll find out who the real Panthers are.” - AAP
LAST weekend witnessed the culmination of another Ducks’ year, with Henry Willcockson batting well below his age and taking the points in the final of the 50-metre Freestyle after Peter Allan got a little bit enthusiastic and broke his time.
Judy Walsh recently stepped into the Publicity Officer seat following the transfer of Janine Gardner and her family to the mid-north coast, and here picks-up the Duck’s feathers on the last day of Club Champs.
“The old-time Ducks’ adage, ‘you can come last, and
still win!’ came to the fruition when Mark Scullard and Louise Taylor came in last in the final of the 2 x 25-metre Backstroke/ Breaststroke Brace Relay. Alas, the rest of the field had all broken their times and Mark and Louise were declared the winners,” Judy said.
Also, one of the club stalwarts picked up a big win to match a special occasion 0- almost!
“Brian Schloeffel showed no sign of slowing down after just celebrating a big birthday milestone. He touched first
in the final of the 50-metre Breaststroke, but he too broke his time and Mark Scullard scored another win by default,” she added.
In the closest-to-time 25-metre Backstroke event, Judy Walsh came in just 0.04 seconds off her time with Allan Quinn on 0.07 and Glen Smith on 0.17 seconds coming-in third.
This Sunday will see the start of the new season with the Blues Meats Trophy race, the April monthly meeting, and lunch in the RSL Club afterwards.




By GEOFF MANN
BUSINESSMAN and race lover, David Ringland, wife Heather, and former Test leg-spinner commentator, and sports personality, Kerry (“Skull”) O’Keefe, will be donning the top-hat and tails for their appearance at the home of racing on Saturday.
“Ringers” and Skull have not stopped chortling since their brilliant runner, “Gallant Star”, hot-tailed it to a fourlengths win in the Western Racing Championships Qualifier at Coonamble recently, and they’re now aiming for a potential $1 million race-day payout in the final.
Dave told me after the Coonamble gallop, that his sprinter is very special, and the win meant everything. “Fantastic! I was awed by the horse. It was an extraordinary win.”
Both Dave and Kerry expressed their surprise with how the race panned-out.
“’Gallant’ came-out and led from the start which is not its normal ‘go’, so I was a bit nervous for a while,” Dave said.
Wasn’t sure if it was going to hang on but the further it went, the stronger Gallant looked, it was such a thrill to be part of this journey with the horse,” he added.
David has been involved in agricultural businesses across the west and was happy to share the success with plenty of his former customers in Coonamble.
Race-caller Col Hodges was enthused by the gallopers all-the-way win at Coonamble, citing it as one of the most dominant he has seen on western tracks for many years.
“Gallant Star was initially bought at auction for $200,000 but, after a very poor couple of starts with one of the leading stables in the metro, it was sent back and David Ringland and Kerry O’Keefe picked it up for around $30,000,” Col recalled.
It has now won over $700,000 so a pretty fair return, one would think!” he added.
Trainer Brett Robb has at least two horses in the field with “Rouge Moulin” chasing Gallant Star home in the Qualifier and a couple of others on hand if there are any scratchings.












































































